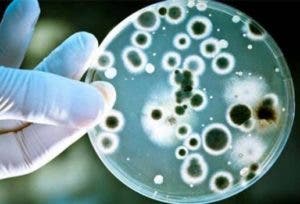

Las infecciones vaginales pueden provocar alteraciones tanto en el área de la vagina como en la vulva. Es importante que estés informada acerca de cuáles son las infecciones vaginales más comunes y las causas que suelen desencadenarlas con mayor frecuencia. De este modo, será más fácil que puedas prevenirlas.
Causas de las infecciones vaginales
Algunas mujeres las sufren con mayor frecuencia; sin embargo, no necesariamente implica una mala higiene, malos hábitos o prácticas sexuales de riesgo.
- No cambiar de preservativo
Aunque no está ligado directamente a la aparición de infecciones vaginales, se considera una de sus causas cuando se mantienen relaciones sexuales anales y vaginales sin cambiar de preservativo.
Lo que ocurre en estos casos es que las bacterias fecales son diseminadas desde el ano hasta la vagina. Para evitar el problema, es importante cambiar el condón si deseas realizar ambas prácticas sexuales.
- Antibióticos
Esto suena contradictorio, pues, en teoría, los antibióticos buscan eliminar agentes causales de enfermedades. Sin embargo, puedes experimentar infecciones vaginales porque este tipo de fármacos afecta tanto a las bacterias beneficiosas (flora bacteriana) como a las dañinas, lo que nos vuelve más susceptibles a desarrollar infecciones fúngicas.
- Alteración hormonal
Los cambios hormonales también pueden ocasionar infecciones vaginales por hongos debido al aumento de estrógenos en el organismo. Los momentos más susceptibles son durante el embarazo, bajo terapia hormonal o durante la menopausia.
- Altos niveles de glucosa en sangre
El gusto por el dulce no es exclusivo de los humanos, también a las levaduras les encanta, por lo que existe una conexión entre la diabetes y las infecciones por levaduras. Es importante llevar una dieta baja en grasas y azúcares, tanto para mejorar la salud como para prevenir determinadas enfermedades.
En caso de padecer diabetes, debes asegurarte de mantener tus niveles de glucosa dentro del rango fisiológico para evitar infecciones vaginales, entre otras molestias.
- Ropa de materiales sintéticos
Como todos sabemos, los sitios cálidos, húmedos y poco oxigenados son lugares en los que las bacterias y los hongos causantes de las infecciones se desarrollan con mayor facilidad. En esta categoría encontramos:
Prendas muy ajustadas (pantalones, shorts, etcétera).
Ropa interior de materiales sintéticos.
Pantalones o leggins de licra o de otras telas que no permiten que haya una buena transpiración.
Todos ellos crean un ambiente perfecto para el desarrollo de microorganismos en la zona genital, especialmente de las levaduras. Si te gustan los pantalones ajustados procura quitártelos o cambiarlos cada 10 horas. Además, es recomendable que revises la etiqueta y elijas aquellos fabricados con algodón en un 50 % como mínimo.
Tipos de infecciones vaginales
No todas las infecciones vaginales son iguales. Cada una tiene características distintas y debe ser tratada de forma particular.
Micosis vaginal o infección por hongos
Es el caso de la candidiasis. Las infecciones fúngicas son las más comunes. Concretamente, la candidiasis suele producir:
Picazón.
Flujo vaginal espeso.
Enrojecimiento en vagina y vulva.
Su tratamiento es sencillo en la mayoría de los casos. Puedes comprar óvulos o cremas que la combaten en cualquier farmacia.
Vaginosis bacteriana
Es común en mujeres en edad reproductiva. La vaginosis aumenta el riesgo de desarrollar enfermedades de transmisión sexual. Se caracteriza por:
Dolor al orinar.
Picazón y dolor vaginal.
Secreción descolorida o de color blanco.
Secreción de flujo vaginal con olor a “pescado” tras mantener relaciones sexuales.
Infecciones vaginales por tricomonas
Es ocasionada por un agente microbiano llamado Trichomonas vaginalis. Este tipo de infección debe ser tratada con antibióticos, puesto que se contagia a través de las relaciones sexuales. Sus características son las siguientes:
Olor a moho.
Ardor y picazón vaginal.
Secreción de color amarillo verdoso
Clamidiasis
Se trata de una infección de transmisión sexual. No solo es capaz de afectar al área genital, también puede ocasionar otras enfermedades como artritis, neumonía o conjuntivitis. Da lugar malos olores en el flujo vaginal, que en estos casos adopta un color blanquecino.
Infección vaginal de tipo viral
Este tipo de infección es ocasionada por el virus del herpes simple. Además de la irritación, aparecen ampollas en el área genital que se convierten en úlceras.
Otro motivo por el que aparece este tipo de infección es el virus del papiloma humano que ocasiona verrugas genitales. En cualquiera de los dos casos es importante acudir al médico.
Ahora que ya conoces cuáles son las infecciones vaginales más comunes, sus causas y sus síntomas, es momento de que comiences a cuidarte mejor (si aún no lo haces). Ten en cuenta que, en muchas ocasiones, la prevención es el mejor remedio que hay.
